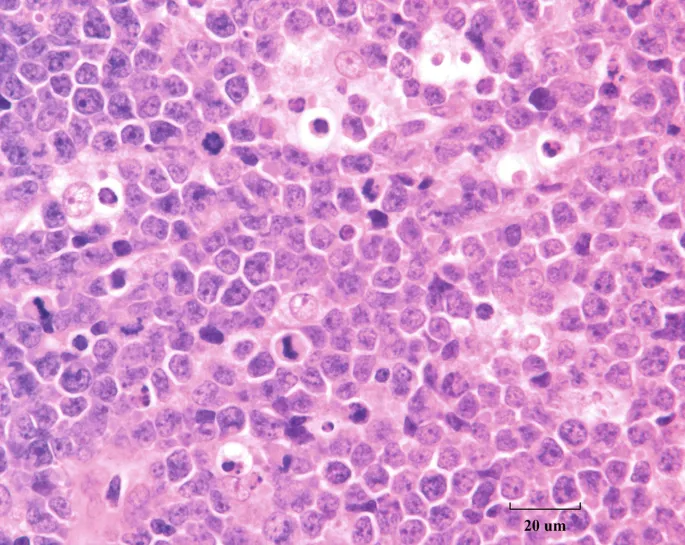
Burkitt Lymphoma: Starry Sky Pattern

EBV Essentials - The Cancer-Causing Kiss
- Epstein-Barr virus (HHV-4) primarily infects B-lymphocytes via the CD21 receptor, establishing a latent infection.
- Viral proteins (e.g., LMP1, EBNA-2) promote cell proliferation and inhibit apoptosis, contributing to oncogenesis.
⭐ Burkitt lymphoma is classically associated with a t(8;14) translocation, placing the c-myc oncogene under the control of the highly active immunoglobulin heavy chain enhancer.
Viral Oncogenesis - Hijacking Host Cells
- Primary Targets: B-lymphocytes (via CD21 receptor) and nasopharyngeal epithelial cells.
- Mechanism: EBV establishes latency, expressing oncoproteins that drive cell proliferation and survival.
- Key Viral Oncoproteins:
- LMP-1 (Latent Membrane Protein 1): Mimics a constitutively active CD40 receptor. It activates NF-κB and JAK/STAT pathways, upregulating survival proteins like BCL-2 and preventing apoptosis.
- EBNA-2 (EBV Nuclear Antigen 2): A potent transactivator that turns on host genes, including Cyclin D and the MYC proto-oncogene, promoting cell cycle progression.

⭐ In Burkitt Lymphoma, a t(8;14) translocation places the MYC oncogene under the control of the highly active immunoglobulin heavy chain (IgH) promoter, leading to massive overexpression.
Malignancy Spectrum - The Usual Suspects
-
Burkitt Lymphoma
- Caused by translocation of the c-myc gene, t(8;14).
- Histology: Classic "starry sky" appearance from macrophages phagocytosing apoptotic tumor cells.
- Forms: Endemic (African, jaw mass) vs. Sporadic (abdominal mass).
-
Nasopharyngeal Carcinoma
- Undifferentiated carcinoma with lymphoid stroma (lymphoepithelioma).
- Presents with nasal obstruction, epistaxis, or metastatic neck mass.
⭐ Strongly associated with Southern Chinese ancestry.
-
Hodgkin Lymphoma
- Most commonly the mixed cellularity subtype.
- EBV is found in the diagnostic Reed-Sternberg cells in about 40-50% of cases.
-
Primary CNS Lymphoma
- Occurs almost exclusively in severely immunocompromised patients (e.g., HIV/AIDS with CD4 < 50).
- Presents as ring-enhancing lesions on brain MRI, often solitary.
Clinical Toolkit - Diagnosis & Management
- Diagnosis
- Serology: Anti-VCA (IgM, IgG), anti-EBNA establishes exposure.
- Histopathology (Biopsy): Definitive. Look for characteristic cells (e.g., Reed-Sternberg in Hodgkin).
- Molecular: PCR for EBV DNA in plasma or tissue; FISH for translocations.
- Management
- Tailored to the specific cancer.
- Chemotherapy: Standard for lymphomas (e.g., R-CHOP for Burkitt, ABVD for Hodgkin).
- Radiation: Primary modality for nasopharyngeal carcinoma (NPC), often combined with chemotherapy.
⭐ Burkitt Lymphoma shows a classic t(8;14) translocation, overactivating the c-myc oncogene.
High‑Yield Points - ⚡ Biggest Takeaways
- EBV infects B-cells, where it establishes latency, driven by the oncogene LMP-1.
- LMP-1 mimics a constitutively active CD40 receptor, promoting B-cell proliferation and upregulating BCL-2 to prevent apoptosis.
- Strongly associated with endemic Burkitt lymphoma (t(8;14); c-myc), nasopharyngeal carcinoma, and mixed-cellularity Hodgkin lymphoma.
- The cause of primary CNS lymphoma in immunocompromised patients, especially in the context of HIV/AIDS.
- Diagnosis confirmed by detecting EBV DNA or EBNA-1 in tumor cells.
Unlock the full lesson and continue reading
Signup to continue reading this lesson and unlimited access questions, flashcards, AI notes, and more